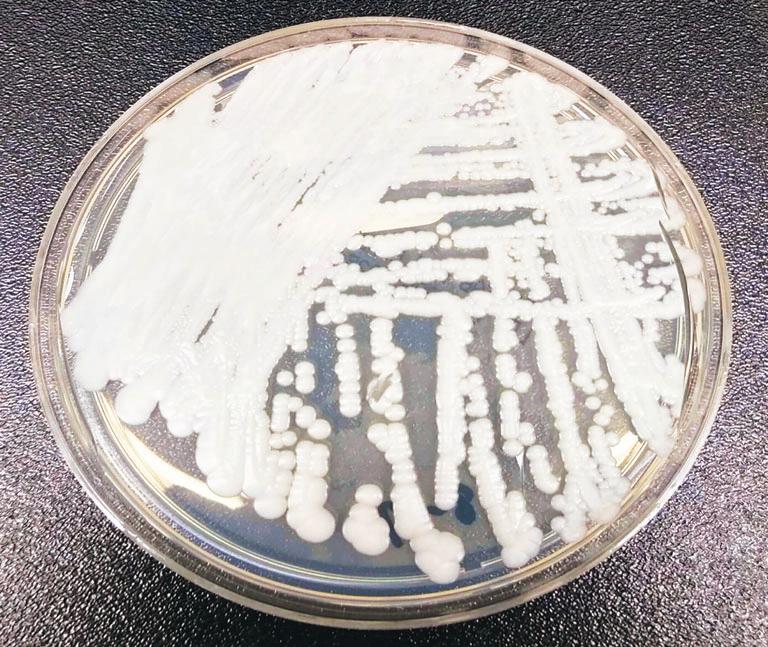

Biden at 58th Anniversary of “Bloody Sunday”
By Brandon Patterson
The annual pilgrimage commemorates the events of March 7, 1965, when civil rights demonstrators attempting to cross the Edmund Pettus Bridge from Selma to Montgomery were met by police officers and white counter demonstrators who attacked them as they marched for voting rights. Civil rights legends including Rev. Jesse

Jackson, Martin Luther King III, and Rev. Al Sharpton, joined congress members including Rep. Jim Clyburn and Rep. Maxine Waters, and many other people who traveled to Selma to commemorate the event.. Biden decried attacks on voting rights from conservative Supreme Court justices and state legislatures and renewed his call for strengthening voting rights with the John Lewis Voting Rights
Advancement Act, named for the late congressman who, at age 25, was among those attacked on Black Sunday. Lewis was then chairman of the Student NonViolent Coordinating Committee (SNCC) and helped plan the march, which spurred the passing of the Voting Rights Act of 1965.
“The right to vote — the right to vote and to have your vote counted is the threshold of democracy and liberty,” said Biden.“With it,
anything is possible. Without it — without it nothing is possible. And this fundamental right remains under assault.” “We must remain vigilant,” he said. Brenda Knight, cofounder of Ladies in Red, a San Franciso Bay Area organization that travels around the country with seniors to learn about African American history, told the Oakland Post the weekend included a Foot Soldiers
Breakfast honoring those who marched on Blood Sunday, an awards ceremony, a film screening, and educational panels.
Knight said, “If it wasn’t for the foot soldiers, we wouldn’t have rights. If our children understood how many people died for their rights, they would vote more. If our kids know the history, they would stop taking our voting rights for granted.”
Knight said
commemorating anniversaries like Bloody Sunday was even more important considering recent book bans and attempts to ban African American history in schools. “Our history is American history,” she said. “We have to do what we need to do to make sure our history is told. Because they’re taking the books. We can’t stop talking.” This Black Press USA article originally appeared in the Oakland Post
Cathay Williams was born to an enslaved mother and a free father in Independence, Missouri in 1844. During her adolescence, she worked as a house slave on the Johnson plantation on the outskirts of Jefferson City, Missouri. In 1861, Union forces occupied Jefferson City during the early stages of the Civil War. At this time, captured slaves were officially designated as contraband and some served in military support roles such as cooks, laundresses, or nurses.
Before her voluntary enlistment, at just 17 years old, Williams served as an Army cook and a washerwoman. In this role she accompanied the infantry all over the country. Williams served under the service of General Philip Sheridan and witnessed the Red River Campaign and the Battle of Pea Ridge.
Despite the prohibition against women serving in the military, Williams enlisted in the U.S. Regular Army under the false name of “William Cathay” on November 15, 1866. She enlisted for a three-year engagement, passing herself off as a man. Williams was assigned to the 38th U.S. Infantry Regiment after she passed the cursory medical examination. Though this exam should have outed her as a woman, the Army did not require full medical exams at this time.
Shortly after her enlistment, she contracted smallpox and was hospitalized. Williams rejoined her unit in New Mexico. There, possibly due to the effects of smallpox, the heat, or the years of marching, her body began to show signs of strain. Due to her frequent hospitalization, the post surgeon finally discovered she was a woman and informed the post commander. She was honorably discharged by her commanding officer, Captain
Charles E. Clarke on October 14, 1868. Though her disability discharge meant the end of her tenure with the Army, her adventure continued. She signed up with an emerging all-black regiment that would eventually become part of the legendary Buffalo Soldiers.
Following her discharge, Williams went on to work as a cook at Fort Union, New Mexico (now Fort Union National Monument) and later moved to Pueblo, Colorado. Though she married, it ended badly after her husband stole her money and a team of horses. Williams had him arrested and then moved to Trinidad, Colorado, where she worked as a seamtress. It was during this time that her story first became public. A reporter from St. Louis heard rumors of a female African-American who had served in the army and came to interview her. Her life and military service narrative was published in the St. Louis Daily Times on January 2, 1876.
Around 1889 or 1890, Williams entered a local hospital and applied for a disability pension based on her military service. Though
there was a precedent for granting pension to female soldiers, (Deborah Sampson, Anna Maria Lane and Molly Williams disguised themselves as men in the Revolutionary War), Williams request was denied. In September 1893, a doctor examined Williams. She suffered from neuralgia and diabetes, and had all her toes amputated and walked with a crutch. The doctor decided that she did not qualify for disability payments.The exact date of her death is unknown, but it is believed she died shortly after she was denied.
What Makes Cathay
An American Hero:
Williams

Though over 400 women served in the Civil War posing as male soldiers, Williams was the first African American woman to enlist and the only documented woman to serve in the United States Army, while disguised as a man, during the Indian Wars. Williams is also the only known female Bu

Delayed, not denied: Vietnam veteran Col. Paris Davis finally receives Medal of Honor
By Conway Jones
Col. Paris Davis, U.S. Army (Retired), was awarded the Medal of Honor on Friday on March 3, 2023, at the White House. Davis was presented with the award by President Joe Biden.

The 83-year-old former Green Beret was finally honored for his actions in Binh Dinh Province, South Vietnam on June 18, 1965. The award came more than half a century after Davis risked his life to save some of his men by fighting off the North Vietnamese. The belated recognition came after the recommendation for his medal was lost, resubmitted — and then lost again. In 2016, advocates for Davis’ award re-created and resubmitted the paperwork.
“You are everything this medal means,” Biden told Davis. “You’re everything our
nation is at our best. Brave and big-hearted, determined, and devoted, selfless and steadfast.”
At a later ceremony in the Pentagon hosted by Deputy Secretary of Defense Kathleen H. Hicks, Davis, the most recent recipient of the Medal of Honor, was inducted into the Pentagon’s Hall of Heroes.
The colonel spoke of his two tours in Vietnam. “These experiences impacted me and my view about the importance of service, dedication and teamwork, then and now,” he said through his daughter. “I am so proud to be an American soldier and a Green Beret. I am grateful for what the Army provided me and what America has given me — opportunity, purpose and pride.
Davis is one of only four service members in U.S. military history to receive both the Soldier’s Medal and the Medal of Honor.
Davis was born
in 1939, in Cleveland, Ohio. Following his 26year military career, Davis published the Metro Herald newspaper in Alexandria, Va., where he currently lives, for 30 years. The newspaper reported on community news and civil rights issues. …The Medal of Honor was created during the American Civil War and is the highest military decoration presented by the United States government to a member of its armed forces. Of the 3,470 Medals of Honor awarded as of June 2015, 92 have been awarded to African-American recipients. Twenty-six African Americans earned the Medal of Honor during the American Civil War. The post Delayed, Not Denied: Vietnam Veteran Col. Paris Davis Finally Receives Medal of Honor first appeared on Post News Group. This article originally appeared in Post News Group.
President Joe Biden joined civil rights leaders, congressmembers, and Black Americans from across the country in Selma, Alabama on Sunday to mark the 58th anniversary of Bloody Sunday.
Williams’ determination
demonstrates
feats women
simply trying to live their lives. Image courtesy of U.S. Army Cathay Williams Cathay Williams joined famed Buffalo Soldiers as a man President
awarded the Medal of Honor to retired U.S. Army Colonel Paris Davis for his remarkable heroism during the Vietnam War on March 3, 2023. AMERICAN HEROES Vol. 50 No. 13• The Journal For Community News, Business & The Arts • insightnews.com Vol 50 No 13• The Journal For News, Business & The Ar ts • insightnews com March 27, 2023 - April 2, 2023 March 27 2023 - 2 2023 INSIGHT NEWS IS AUDITED BY THE ALLIANCE FOR AUDITED MEDIA TO PROVIDE OUR ADVERTISER PARTNERS WITH THE HIGHEST LEVEL OF MEDIA AS SURANCE. I N S I G H T N E W S I S A U D I T E D B Y T H E A L L I A N C E F O R A U D I T E D M E D I A T O P R O V I D E O U R A D V E R T I S E R P A R T N E R S W I T H T H E H I G H E S T L E V E L O F M E D I A A S S U R A N C E Insight News News
ffalo Soldier.
to serve her country
the extraordinary
have accomplished
Joe Biden
2. That the Governor hold his appointed State Commissioners and the state departments they lead accountable for measurable and reportable processes and strategies to eliminate disparities that exist in and that are supported by policies and procedures of state governance.
3. That the Minnesota Legislature prioritize intentional solution making that can occur when Legislators, Committee Chairs and Committees engage Minnesota’s Black community at the table of decision.
4. Housing Invest now in multiple housing options for the Black community to close the home ownership gap.
Multiple housing options are an important part of any community. It provides a safe and affordable place for people to live and can help reduce poverty and homelessness. However, there are many challenges associated with providing low-income housing, such as limited resources, high demand, and the need to ensure that the housing is safe and secure. Minneapolis has one of the widest homeownership gaps in the country between whites and Blacks.
of new businesses among all races do not receive any outside investors. Most people use the equity in their homes to start their firms. This is a huge disadvantage to Black folks in Minnesota because of the home ownership gap. Further, the report stated that minority owned businesses experience higher loan denial probabilities and pay higher interest rates than white-owned businesses even after controlling for differences in credit-worthiness, and other factors. Limited access to investment capital in its many forms is inextricably linked to systemic discrimination in lending, housing, and employment. It cripples Black business development.
2. Employment Invest now in creating employment opportunities for the Black community
In an article published by the Urban Institute, the issue of Black employment was addressed.



It stated that, “while many are heralding the drop in the national Black male unemployment rate, which recently fell below 10 percent for the first time in seven years, joblessness remains much higher in many poor African American communities. It stated that for many low-income Black men, finding and keeping work is a constant struggle, never far from their minds. Black job applicants might not even make it into the queue if they have had an encounter with the criminal justice system. Helping Black folks secure steady employment at decent wages will require resources to break down the institutional barriers that separate people from decent job opportunities and to enable Black people to build the skills needed for well-paying jobs
3. Public Safety
Invest now in Public Safety in the Black community.
Public safety exists to protect citizens, organizations, and communities by preventing them from being in danger and guarding their well-being. Abraham Maslow defined safety in his famous “Hierarchy of Human Needs“. He said that to function as a society public safety is needed. He said this safety goes beyond just physical safety but also safety when it comes to health, money, possessions, and family. Less we forget, there’s an Emotional Impact on Public Safety. When folks feel unsafe, it could have major effects on individuals, their loved ones, and the community they live in. Violence has been way to prevalent in the inner cities of Minneapolis and St. Paul. Playgrounds are unsafe, the streets are unsafe, and the shopping malls are unsafe.
5. Education
Invest now in ensuring that our Black students are educated at the same level as White students.
Dr. Sinclair Grey lll stated that education is without a doubt crucial to the success of our students competing for jobs. Quality education that enforces and reinforces math, science, writing, and cognitive thinking will separate those who desire a prosperous future from those who are simply content with getting by. Yet, in Minnesota, reading test scores for Black students are over 20 points below state average and math test scores are 20 points below state average. Minnesota ranks 50th in the nation for Black students who graduate on time. Minnesota has one of the worst college-readiness gaps in the nation by race and ethnicity – only 25% of Black students are prepared for college. Thus, Black students who attend college must take significantly more remedial courses than their peers as their starting point.
6. Health & Wellness
Invest now in efforts that will impact the health and wellness of the Black community.
The Black community is faced with escalating social, economic, and life-style problems, which threaten the life and well-being of current and future generations of Black people in crisis proportion. The rising number of deaths due to heart disease and stroke, homicide and accidents related to substance abuse, AIDS, cancer, and infant mortality are among the leading culprits. They interfere with prospects of longevity and contribute to joblessness, poverty, and homelessness and further complicate the crisis in the Black community. The magnitude of the problems dictates the need for support from the Minnesota State Legislature.
7. Policy Each member of the legislature, regardless of political affiliation, is involved in setting public policy. These policies should reflect the will of the people and is carried out by those elected to vote. Because of conflicting interests and capacities, some policies have disenfranchised the Black community. There is therefore a need for coherence of interest/capacities in an attempt to pass policies that reflect the needs of the Black community.
Every time another national “quality of life” is broadcast or published about the best places to live in the U.S., Minnesota and the Twin Cities always rank at or near the top. The Atlantic’s Derek Thompson once referred to this as the miracle of Minneapolis.” Likewise, every time those lists are parsed out further, the state and the metro fall all the way to the bottom when it comes to quality of life measures for Black people, or, what some have called the “Two Minnesotas.” But to ensure that all those in our state have the opportunity to thrive, we cannot forget about the communities that have been systematically abused, persistently underrepresented, and long underserved.
Minnesota is now the seventh (7th) worst state in the country for Blacks to live. This dubious recognition alongside the May 2020 murder of George Floyd has brought the State into an era of racial reckoning and has put racial inequity at the center of the national conversation, and Minnesota on the racial map. Today Black folks are more than twice as likely as their white counterparts to live below the poverty line. Additionally, the typical Black household earns just 63 cents for every dollar a typical white household earns, and African American workers are more than twice as likely to be unemployed as white workers.
Using data from the U.S. Census Bureau, 24/7 Wall St. created an index to measure socioeconomic disparities between Black and white Americans to identify the worst states for Black Americans. High on the list of cities that have extremely troubling disparities is Minneapolis-St. Paul. Minnesota’s urban core boast these disturbing rates:
• Black population: 290,210 (8.2% of total)


• Black median income: $36,127 (44.0% of white income)
• Unemployment: 9.2% (Black); 3.2% (white)




• Homeownership rate: 25.2% (Black); 75.5% (white)
• Black poverty rate of 28.3% in the metro area, 5.9% (white)
• Black medium household earn $36,127 a year — the median income among white area households is $82,118.
The profound racial wealth gaps for Blacks in Minnesota is structural, as they are across the United States. Structural racism is inherent in intersecting and overlapping institutions, policies, practices, ideas, and behaviors that give resources, rights, and power to white people while denying them to others. The roots of racial wealth gaps can be traced back centuries through racialized public and private policies and practices, which fueled economic boosts to white families that allowed for intergenerational wealth transfers and created barriers to Black families. Past discrimination and injustices accumulate and build across generations, making it hard for communities that have been harmed to catch up. As one example, the losses from unpaid wages and lost inheritances to Black descendants is estimated at around $20 trillion today. The NAACP Twin Cities 2019 Economic Inclusion Plan states: “There are two Minnesota’s, one white, one Black – separate and unequal.”
Data from the 2019 Prosperity Now Scorecard shows that 40% of Americans are liquid asset poor—meaning they do not have enough in savings to make ends meet at the poverty level for three months ($6,275 for a family of four in 2018). This problem is even more stark when disaggregated by race. 31.7% of white households are liquid-asset poor compared to over 62% of Black households.
Recent trends in Hennepin and Ramsey Counties are moving in the wrong direction. The share of Black families who own a home has declined from 31 percent in 2000 to 21 percent in 2018. The racial homeownership gap in the Twin Cities is the highest in the nation and has only widened over the past two decades, especially in neighborhoods where investors have acquired hundreds of single-family homes to now use as rentals, according to a June 2021 report from the Urban Institute.
Page 2 • March 27 2023 - April 2 2023 March 27, 2023 - 2, 2023• Insight News insightnews.com BLACK MINNESOTA PRIORITIES • Equity in distribution and stewardship of resources • Advancing innovation and collaboration in problem solving • Upending traditional systems • Bringing the voices of community front and center THE URGENCY OF NOW! • Minnesota’s record budget surplus enables addressing disparities in a meaningful way •We demand genuine inclusion in the resource allocation process •We must outline, up front, what this inclusion looks like THREE STEPS BACKGROUND INVEST NOW! 2023 UNITED BLACK LEGISLATIVE AGENDA 1. That Minnesota governor Tim Walz, meets with representatives of Minnesota Black communities t0 affirms Minnesota’s commitment to prioritize disparities elimination in all aspect of Minnesota governance and administration. 1. Business and Economic Development Invest now in Black folks and their abilities to create businesses in the community. An article published by the Brooking Institute stated that the underrepresentation of Black businesses does not come from a lack of will or talent. Rather, the underrepresentation of Black businesses encapsulates a myriad of structural barriers underscoring America’s tumultuous history with structural racism. One of the principal barriers to the growth and development of Black businesses is that Black households have been denied equal opportunities for wealth accumulation. The median Black household’s wealth ($9,000) is nearly one-fifteenth that of non-Black households ($134,520). The article states that 90%
Vince was very instrumental in shaping my son’s character and life focus. Although he lived in Minneapolis, Vince would call my son often during his is formative early teen years and share his wisdom and wise counsel. I will always treasure him and be thankful for his guidance. Carolyn James, San Antonio, Texas Carolyn James I was sorry to learn that my old grad school buddy, Vinny, recently died. I was the Columbia roommate of Bill Sales, and it was through Bill that I met Vinny 59 years ago. The three of us had lots of laughs together, as I did with Vinny myself in the early 2000s when I visited Minneapolis on business. What a great friend! What a great wit! Although we spoke by phone in recent years, and although he always promised to visit New York City again, I guess seeing


Minnesota moving to fortify state status as abortion refuge
Minnesota is moving to fortify its status as a refuge for patients from restrictive states who travel to the state to seek abortions — and to protect providers who serve them.
The state House on Monday passed a bill by a 68-62 vote to prohibit enforcement in Minnesota of laws, subpoenas, judgements or extradition requests from other states against people who get, perform or assist with abortions in Minnesota.
The Senate version passed its first committee test last week.
The House lead author, Democratic Rep. Esther Agbaje, of Minneapolis, said at
a news conference before the debate that a prime example of what supporters are worried about is a Texas law that deputizes individuals to enforce their state’s strict restrictions by allowing them to sue to anyone who helps a patient obtain an abortion elsewhere.
Democratic House Majority Leader Jamie Long, of Minneapolis, said the bill is needed because Texas-style legislation has been introduced in several states that could put Minnesota providers at risk, as well as residents who might help relatives or friends who come to Minnesota for abortions just by picking them up at the airport.

“Before the Dobbs decision last summer, I’d often care for patients from
nearby states like the Dakotas or Wisconsin,” said Dr. Sarah Trexler, chief medical officer at Planned Parenthood North Central States, which performs 70% of the abortions in Minnesota. “But now, for the first time ever, I regularly care for patients from Texas, Alabama, Wyoming, Oklahoma, Louisiana, and the list goes on and on.”
Like Planned Parenthood and other providers, Whole Woman’s Health of Minnesota in Bloomington has also seen a sharp increase in patients from out-ofstate, more than doubling from 2019 to 26% in 2022.
“The most remarkable change has come from Texas, where we only saw 2 patients

from that state in 2019 to 96 from February 2022 to March of 2023,” Amy Hagstrom Miller, president and CEO of Whole Woman’s Health Alliance, said in an email. Democrats made have abortion rights one of their top priorities for Minnesota’s 2023 legislative session. They won a one-seat majority in the state Senate in the November elections while maintaining a wider hold on the House to wind up with pro-choice majorities in both chambers. Democratic Gov. Tim Walz signed a fast-tracked bill in January to enshrine in state statutes abortion rights that had been protected under a 1995 Minnesota
Will Trump be indicted? What we know about the process
The decision whether to indict former President Donald Trump over hush-money payments made on his behalf during his 2016 presidential campaign lies with a Manhattan grand jury that has been hearing evidence in secret for weeks.

An indictment of Trump, who is seeking the White House again in 2024, would be an unprecedented moment in American history, the first criminal case against a former U.S. president.
Law enforcement
officials are bracing for protests and the possibility of violence after Trump called on his supporters to protest ahead of a possible indictment.
An indictment could also test a Republican Party already divided over whether to support Trump next year, in part due to his efforts to undermine his 2020 election loss.
Trump denies any wrongdoing and has slammed the Manhattan district attorney’s office probe
as politically motivated.
Here’s a look at the hush-money probe, grand jury process and possible ramifications for his presidential campaign:
WHAT’S THE PROBE ABOUT?
The grand jury has been probing Trump’s involvement in a $130,000 payment made in 2016 to the porn actor Stormy Daniels to keep her from going public about a sexual encounter she said she had with him years earlier. Trump lawyer Michael Cohen paid Daniels, whose real name is Stephanie Clifford, through a shell company before being reimbursed by Trump, whose company, the Trump Organization, logged the reimbursements as legal expenses.
Earlier in 2016, Cohen also arranged for former Playboy model Karen McDougal to be paid $150,000 by the publisher of the supermarket tabloid The National Enquirer, which then squelched her story in a journalistically dubious practice known as “catch-and-kill.”
Trump denies having sex with either woman.
Trump’s company “grossed up” Cohen’s reimbursement for the Daniels payment to defray tax payments, according to federal prosecutors who filed criminal charges against the lawyer in connection with the
payments in 2018. In all, Cohen got $360,000 plus a $60,000 bonus, for a total of $420,000. Cohen pleaded guilty to violating federal campaign finance law in connection
him again face to face was not to be. I will always miss him. Through Vinnie and Bill, I met Charlie Lynch at Columbia too. Vinnie always knew where the parties were, and one enduring memory I have is of the four of us, underdressed, freezing our butts off on a street corner somewhere trying to find a taxi back to campus after a party.
Pew Center for Research noted that approximately 25% of Latino/a/x/e’s self-identified as Afrolatin, and among those 1/3 identified as Black, effectively 4-6 million self-idenified in the U.S. In changing the Categorizations, it will severely hamper any further opportunity we, the Afrolatinx community has to be counted and recognized.
AfroLatino Project

Once POTUS Biden racializes you by making Hispanics/Latinos/Latinx a “race,” you will find yourself ensnared in the battle for racial justice and equality that Black people of African descent and Indigenous Americans have been battling for over 300 years, and still today. Becoming a “race” in a country where it is used to disenfranchise is not all that.
Indeed, making Hispanics a race on top of the immigrant status, will subject you (those unable to pass for “white”, to prejudices
rooted in biology in addition to citizenship status challenges that can never be reversed!



Becoming “White” in America
The Irish did it, yet still face religious stigma, and the Jews did it, yet Anti-Semitism is pervasive and resurfacing. The rich Cubans who abandoned their country after the Cuban Revolution in 195– like to pretend they are “white.” They marry white women, anglicize the pronunciation of their names and spend a lot of energy subjugating American Black people, and their own Indigenous and Afrolatinos people to show white Americans that they fit, and prove to their real white (American) masters that they have learned to authentically hate themselves, their heritage, and anyone, regardless of national origins, who is nonwhite. I imagine it is difficult for people like DeSantis and Rubio to go home every night and peer into the mirror chanting the mantra - I’m white, I’m white, when their native language, culture and history say otherwise!
The Continuing Rule of White Masters/Massa in the 21st Century? Now ask yourself, who gave this lowly white
insightnews.com Insight News •March 27 2023 - April 2 2023 March 27, 2023 - 2, 2023• Page 3
VINCE 4
photo/Alex Brandon
women’s constitutional right to abortion. 1
Former President Donald Trump speaks at the Conservative
Political
Action Conference, CPAC 2023, March 4, 2023, at
National Harbor
in Oxon
Hill, Md. No Republican has done more to restrict abortion rights than Trump. But in the early days of the 2024 presidential contest, no Republican has worked harder to avoid the issue than the former president either. More than his GOP rivals, Trump is sidestepping the polarizing topic just nine months after he celebrated the Supreme Court’s stunning decision to strip
ABORTION 4 AP
Democratic Minnesota
Esther
speaks at a news
Minnesota
Capitol on Monday, March 20, 2023, in St. Paul, Minn. The state House passed the bill by a 68-62 vote to prohibit enforcement in Minnesota of laws, subpoenas, judgements or extradition requests from other states against people who get, perform or assist with abortions in Minnesota. Culture and Education Editor By
Reflections: Remembering Vincent Carlo DeLusia Hispanics/Latinos Beware Becoming a “race” is not all that HISPANICS 5 TRUMP 5
Photo/Steve Karnowski) photo/Steve Karnowski
state Rep.
Agbaje
conference ahead of a vote on her bill in the
State
Irma McClaurin, PhD
Vincent Carlo DeLusia
Press Insight News Insight News Vol 50 No 13• The Journal For Community News, Business & The Arts • insightnews com Vol. 50 No. 13• The Journal For Business & The Arts • insightnews.com March 27, 2023 March 2023 - April 2, 2023 - 2023 I N S I G H T N E W S I S A U D I T E D B Y T H E A L L I A N C E F O R A U D I T E D M E D I A T O P R O V I D E O U R A D V E R T I S E R P A R T N E R S W I T H T H E H I G H E S T L E V E L O F M E D I A A S S U R A N C E INSIGHT NEWS IS AUDITED BY THE ALLIANCE FOR AUDITED MEDIA TO PROVIDE OUR ADVERTISER PARTNERS WITH THE HIGHEST LEVEL OF MEDIA AS SURANCE. I2H Prostate cancer treatment can wait for most men, study finds PAGE 5 PAGE 7 Business Abdirahman Kahin, CEO & owner of Afro Deli & Grill is the Minnesota small business person of the year
By Alanna Durkin Richer and Meg Kinnard Associated Press
By Steve Karnowski Associated
Education
House bill would mandate smaller K-12 class sizes, boost funding formula
By Steve Abrams House Session Daily
Class sizes in Minnesota schools are spiraling out of control, parents and educators say. Classrooms of 30 or 35 students are becoming increasingly common, impairing educational outcomes and causing teacher burnout.

Rep. Zack Stephenson (DFL-Coon Rapids) sees this as a dire situation that requires drastic measures.
“Class size matters.
Too many students in a classroom makes individualized attention virtually impossible,” he said. “Small class sizes have long-term benefits for students, particularly in the early years of education.”
He sponsors HF2619, which would mandate class size ratios in K-12 schools and provide dedicated funding to achieve this end.
On Friday, the House Education Finance Committee laid over the proposal, as amended, for possible inclusion in an omnibus bill.
Stephenson’s bill would require districts to hire many more teachers and paraprofessionals in order to reduce class sizes. The state would cover these costs by increasing the general education basic formula starting in fiscal year 2024. The formula allowance for school districts would jump from $6,863 per adjusted pupil unit to $8,236, a 20% increase. For future years, basic formula increases would be tied to inflation, as measured by the Consumer Price Index for urban consumers. Districts would be required to reduce class sizes via plans negotiated with the teacher unions. Agreed upon class size ratios would have to be no greater than:
17 students to one educator for kindergarten through grade 3;
21 to one for grades 4 through 9; and

23 to one for grades 10 through 12.
The proposal contrasts with HF439. That bill, heard by the committee last month, would raise the basic formula
5% annually in the next two fiscal years but makes no mention of class size. Future increases would also be indexed to inflation, starting in fiscal year 2026.
Several teachers testified in support of Stephenson’s bill, highlighting both the teaching and learning difficulties associated with overcrowded classrooms.
“The most important resources in Minnesota classrooms are time and trusting relationships between students and educators,” said Greta Callahan, a kindergarten teacher and president of the Minneapolis Federation of Teachers.
“When class sizes get smaller or student-to-educator ratios improve, good things happen.”
Rep. Ron Kresha (R-Little Falls) opposes the bill. He argued it will constrain school budgets to meet the class size mandate, strip districts and educators of the ability to determine what’s best for them on the local level, and cost the state $3 billion to $4 billion. His comments prompted a rebuttal from
Rep. Sydney Jordan (DFLMpls), who noted that state law currently precludes the negotiation of class size ratios during collective bargaining. However, she is sponsoring
HF1691, which would place class sizes under the “terms and conditions of employment” to be hammered out at the bargaining table. Whether providing a funded mandate like Stephenson

suggests or simply allowing for negotiation, she insists something must be done now to reduce class sizes.
Emergency fund for MN college students in need of a major boost, advocates tell higher ed committee
By Rob Hubbard House Session Daily
The early 2020s have been a tough time to be a college student. In addition to all the difficulties that accompanied the pandemic and the Zoomification of educational offerings, life became considerably more insecure for students in the areas of housing, food and transportation.
The Office of Higher Education has an emergency fund available for students in immediate need of help in those areas, but its current base appropriation is only $319,000 per year. That would grow greatly under HF467.
Sponsored by Rep. Mohamud Noor (DFL-Mpls), the bill, as amended, would appropriate $7.55 million per year toward emergency assistance for postsecondary
students. Of that, $5 million per year would go to the Minnesota State system, while $2 million would be for the University of Minnesota. Another $500,000 would be set aside for tribal colleges and other nonprofit institutions eligible for state financial aid.
Funds appropriated would be available until spent, but, at the end of the biennium, institutions would be required to return any unused funds to the Office of Higher Education.
On Tuesday, the House Higher Education Finance and Policy Committee laid the bill over for possible inclusion in its omnibus bill.
“What we’ve heard from students is that one financial emergency can cause a significant interruption to their academic journey,” said Maya Sullivan, dean of students at Metropolitan State University.
“National studies have shown
that emergency financial support makes a significant difference in the ability of students to remain enrolled, succeed academically, and ultimately to complete their degree program, and then
University of Minnesota Campus. The Office of Higher Education has an emergency fund available for students in immediate need of help in those areas, but its current base appropriation is only $319,000 per year. That would grow greatly under HF467.

to contribute positively to our workforce and economy.”
“College students tend to live on very tight financial budgets that they have to stick to to make ends
meet every month,” said Siya Sakhardande, a member of undergraduate student government at the University of Minnesota. “This may mean that, towards the end of their
budget period, they’re running out of food or request to pay their rent or tuition later because the money just isn’t there.” Rep. Kristin Robbins (R-Maple Grove) wanted to know what accountability measures are in place for students receiving the grants.
“The money goes to the institutions and the institutions run their own individualized programs,” said Nekey Oliver, director of grants and government relations for the Office of Higher Education.
“They know their students best. … Most students are applying for transportation emergencies and housing emergencies. So institutions can issue checks directly to vendors or repair shops, and not directly to the student.”
Supreme Court decision. Texas and Oklahoma allow private citizens to sue people they believe have helped someone get an abortion. Minnesota has already adopted
INSIGHT NEWS
www.insightnews.com
Insight News is published weekly, every Monday by McFarlane Media Interests.
Editor-In-Chief Al McFarlane
Publisher Batala-Ra McFarlane
Associate Editor & Associate Publisher


B.P. Ford
Culture and Education Editor
Dr. Irma McClaurin, PhD.
Associate Editors Afrodescendientes
Jesús Chucho Garcia
Mestre Yoji Senna DaBahia
Columnist Brenda Lyle-Gray
Book Review Editor W.D. Foster-Graham
Sports Editor Leahjean M. Denley
Content & Production Manager Sunny Thongthi Yang
Distribution/Facilities
Manager Charles Royston
Receptionist
Lue B. Lampley
Intern Naomi Thomson
Photography
Uchechukwu Iroegbu Lou Michaels Roy Lewis - Washington D.C.

Abortion From 3 Vince From 3
Artist Donald Walker Contact Us: Insight News, Inc.
Marcus Garvey House 1815 Bryant Ave. N. Minneapolis. 55411 Ph.: (612) 588-1313
Fax: (612) 588-2031

Member: Minnesota Multicultural Media Consortium (MMMC) Minnesota Newspaper Association (MNA)


National Newspaper Publishers Association (NNPA)

Postmaster: Send address changes to McFarlane Media Interests, Marcus Garvey House 1815 Bryant Avenue North, Minneapolis,
some protections that apply to those people under an executive order that Walz signed last June. And Democratic Attorney General Keith Ellison pledged that his office wouldn’t cooperate with other states seeking to prosecute women who come to Minnesota for abortions. Several other states, including California and Colorado have also adopted safe haven protections for patients traveling to seek abortions, either by executive order or by statute.
A more contentious bill working its way through the Minnesota House and Senate
would repeal a long list of state statutes restricting abortion rights — such as 24-hour waiting period and parental notification requirements — that a district judge declared unconstitutional last July. It’s meant to ensure that appellate courts can’t restore those restrictions. Long demurred on when that bill might come up for a House floor vote. Asked if supporters now have the votes to pass it, he replied, “We’ll have the votes when we bring it to the floor.” Republican critics of the various bills argue they’ve
already left Minnesota with essentially no restrictions on abortion at all — at any stage of pregnancy. But their efforts to scale back the legislation and maintain some limits have all failed. Republican Rep. Peggy Scott, of Andover, said the bill passed Monday will give Minnesota a “black eye” by making it a destination and sanctuary for people seeking to end their pregnancies.
“We are going to reward breaking the law, we are going to reward behavior that leads to felony convictions in other states. We’re going to say,
‘Come to Minnesota, we’ll have you, we’ll take you,’” GOP Rep. Anne Neu Brindley said during the debate. “Folks, it’s wrong.” Trisha Ahmed contributed to this story from Minneapolis. Ahmed is a corps member for the Associated Press/ Report for America Statehouse News Initiative. Report for America is a nonprofit national service program that places journalists in local newsrooms to report on undercovered issues. Follow her on Twitter: @ TrishaAhmed15
I guess we found the cab because I lived to tell the story, but that night I remember thinking that I might not survive. Fortunately, Vinnie’s wry commentaries on girls, Columbia, and the state of world affairs kept us laughing and energized. I will always miss him. And what a storyteller!
(Charlie, in his comments, calls him a raconteur, and that may be a better word to use, Charles.) Vinnie had funny things to say about seemingly everything. Even about the use of salt as a food preservative in many cultures. He delved into that topic at a Sri
Lankan restaurant when I was in town -- the same Sri Lankan place he took you to, Charles? – and, out of an abundance of caution, I ordered the mild version of something, so as not choke on a dish that was super hot. When the food arrived, I found myself gulping down water after every bite, nonetheless. The waitress thought it was funny. Vinnie did too. In fact, all three of us had a good laugh about it. I will always miss him.
Robert Carpenter
I met Vince in September 1964 when he began Columbia University’s School of International Affairs and I had entered its School of General Studies, intent upon studying French and German to get a degree in Comparative Literature.
A Bronx native, he was extremely generous in introducing students not from New York City to his friends and acquaintances. Our lives were enhanced by his being a liaison. In fact, my first girlfriend in the city, and five years later, the woman I married were both made possible by Vinny. I valued our 25 years of friendship, and although we became estranged, in part due to our own stubborness and heat, I learned so many things from him as a peer. In retrospect, he was the first person to introduce me to some complexities in Latino and West Indian cultures. I learned to be more conferring and genial and forthright in expressing my knowledge after observing him. He was very perceptive and funny, at times due to his
power as a raconteur whose facts at his fingertips and anecdotes could be puffed with some yeast and air. My wife Gayle and I visited with him and Jeanene in the early 1980s in the Twin Cities and he drove us to see Prince’s childhood home, Hubert Humphrey’s grave, the Henepin Avenue entertainment strip, and a Sri Lankan restaurant. Also, we toured areas my wife had lived in as a child. Vince and I both became college educators (I in English) and I regret that there was a breach. However, he is well remembered and appreciated. Truly a unique spirit and accomplisher. We send our sincere condolences to Jeanene and those who loved him dearly.-Charles (and Gayle) Lynch
Page 4 • March 27 2023 - April 2 2023 March 27, 2023 - 2, 2023• Insight News insightnews.com
photo/HaizhanZheng
photo/House Session Daily
Rep. Zack Stephenson’s bill would require districts to hire many more teachers and paraprofessionals in order to reduce class sizes.
Rep. Mohamud Noor (DFL-Mpls)
Superbug fungus cases rose dramatically during pandemic
 By Mike Stobbe AP Medical Writer
By Mike Stobbe AP Medical Writer
U.S. cases of a dangerous fungus tripled over just three years, and more than half of states have now reported it, according to a new study.
The COVID-19 pandemic likely drove part of the increase, researchers at the Centers for Disease Control and Prevention wrote in the paper published Monday by Annals of Internal Medicine. Hospital workers were strained by coronavirus patients, and that likely shifted their focus away from disinfecting some
other kinds of germs, they said. The fungus, Candida auris, is a form of yeast that is usually not harmful to healthy people but can be a deadly risk to fragile hospital and nursing home patients. It spreads easily and can infect wounds, ears and the bloodstream. Some strains are so-called superbugs that are resistant to all three classes of antibiotic drugs used to treat fungal infections.
It was first identified in Japan in 2009 and has been seen in more and more countries. The first U.S. case occurred in 2013, but it was not reported until 2016. That year, U.S. health officials reported 53 cases. The new study found
cases have continued to shoot up, rising to 476 in 2019, to 756 in 2020, and then to 1,471 in 2021. Doctors have also detected the fungus on the skin of thousands of other patients, making them a transmission risk to others. Many of the first U.S. cases were infections that had been imported from abroad, but now most infections are spread within the U.S., the authors noted. The Associated Press Health and Science Department receives support from the Howard Hughes Medical Institute’s Science and Educational Media Group. The AP is solely responsible for all content.
FILE - This undated photo made available by the Centers for Disease Control
shows a strain of Candida auris
Prostate cancer treatment can wait for most men, study finds
 By Carla K. Johnson AP Medical Writer
By Carla K. Johnson AP Medical Writer
Researchers have found longterm evidence that actively monitoring localized prostate cancer is a safe alternative to immediate surgery or radiation.
The results, released Saturday, are encouraging for men who want to avoid treatment-related sexual and incontinence problems, said Dr. Stacy Loeb, a prostate cancer specialist at NYU Langone Health who was not involved in the research.
The study directly compared the three approaches — surgery to remove tumors, radiation treatment and monitoring. Most prostate cancer grows slowly, so it takes many years to look at the disease’s outcomes.
Trump
From 3
with the payments. Federal prosecutors say the payments amounted to illegal, unreported assistance to Trump’s campaign. But they declined to file charges against Trump himself.
Manhattan District Attorney Alvin Bragg’s team appears to be looking at whether Trump or anyone committed crimes in New York state in arranging the payments, or in the way they accounted for them internally at the Trump Organization.
BUT CAN A FORMER PRESIDENT BE INDICTED?
In a word, yes. Longstanding Justice Department policy prohibits the federal indictment of a sitting president, but Trump, two years out of office, no longer enjoys that legal shield. And the New York case is not a federal probe anyway.
WHAT IS THIS GRAND JURY?
A grand jury is made up of people drawn from the community, similar to a trial jury. But unlike juries that hear trials, grand juries don’t decide whether someone is guilty or innocent. They only decide whether there is sufficient evidence for someone to be charged. Grand juries exist in the federal court system and in many states.
Hispanics
From 3
man (POTUS Joe Biden), who has authority over OMB (Management and Budget Office), the “power” to redefine an entire continent of Latin America, Central America, and the country of Mexico? Is he God? Or merely another white Wiz of Oz hiding behind the curtain of whiteness?
Hispanic is an invented census term. It is “honorary white” classification for people like DeSantis and Rubio, but it often obscures Afrolatinos, Indigenous, and Asian people of Central and Latin America and some Caribbean Islands, who someimes check the “Other” box.
Becoming “white” may seem a way to navigate the racial landscape of America—but people with origins in Latin and Central America already have a problematic racial history founded on trying to make invisible and erase the Black presence in Latin
“There was no difference in prostate cancer mortality at 15 years between the groups,” Loeb said. And prostate cancer survival for all three groups was high — 97% regardless of treatment approach.
“That’s also very good news.”
The results were published Saturday in the New England Journal of Medicine and presented at a European Association of Urology conference in Milan, Italy. Britain’s National Institute for Health and Care Research paid for the research.
Men diagnosed with localized prostate cancer shouldn’t panic or rush treatment decisions, said lead author Dr. Freddie Hamdy of the University of Oxford. Instead, they should “consider carefully the possible benefits and harms caused by the treatment options.”
Proceedings are closed to the public, including the media. There is no judge present nor anyone representing the accused. Prosecutors call and question witnesses, and grand jurors can also ask questions. In New York, the person who could be indicted may ask for a certain witness, though it’s up to grand jurors. New York grand juries have 23 people. At least 16 must be present to hear evidence or deliberate. Twelve have to agree there is enough evidence in order to issue an indictment. The grand jury may also find there is not enough evidence of a crime or direct the prosecutor to file lesser charges.
Centuries-old rules have kept grand juries under wraps to protect the reputations of people who end up not being charged, to encourage reluctant witnesses to testify, to prevent those about to be indicted from fleeing and to guard against outside pressure.
Grand juries have long been criticized as little more than rubber stamps for prosecutors. Former New York Judge Sol Wachtler famously said that prosecutors could convince a grand jury to “indict a ham sandwich.” Defenders of the process say it is a crucial safeguard against politically motivated prosecutions.
WHO HAS TESTIFIED IN THIS CASE?
One of the final witnesses being called was Robert Costello, who was once a legal adviser to
America—no can do.
The Racialization Agenda You see “race” is not a biological reality—it was/ is created as a social system of classification designed to make sure that white, heterosexual (cisgender) men were always at the top of the food chain. Systems of racialization are predicated on mistaken beliefs that biology created so-called “races.”

To the contrary, it people who established the social classification that has come to known as “races.” Black anthropologist, the late Audrey Smedley, confirms the invention of “race” as a social development.
Race as a mechanism of social stratification and as a form of human identity is a recent concept in human history. Historical records show that neither the idea nor ideologies associated with race existed before the seventeenth century. In the United States, race became the main form of human identity, and it has had a tragic effect on low-status „racial“ minorities and on those people who perceive themselves
A small number of men with high-risk or more advanced disease do need urgent treatments, he added.
Cohen, the government’s key witness in the investigation. The men have since had a falling out, and Costello has indicated that he has information he believes would undercut the credibility of Cohen and contradict his current incriminating statements about Trump.
Costello contacted a lawyer for Trump saying he had information that could be exculpatory for Trump, according to a person familiar with the matter who insisted on anonymity to discuss secret legal proceedings. The lawyer brought it to the attention of the district attorney’s office, which last week subpoenaed Costello’s law firm for records and invited him to testify. He was at the building where the jurors were meeting on Monday, invited by prosecutors, ensuring the grand jury had an opportunity to consider testimony or evidence that could weaken the case for indicting.
Trump was also been invited to testify, but his lawyer has said the former president has no plans to participate.
WHAT ABOUT THE POLITICAL RAMIFICATIONS?
Trump says charges would actually help him in the 2024 presidential contest. Longtime ally Lindsey Graham, senator from South Carolina, said Saturday that District Attorney Bragg “has done more to help Donald Trump get elected.” Florida Gov. Ron DeSantis, considering joining the Republican field, criticizes the Trump investigation
as of „mixed race.“ (Smedley, A. (1998), „Race“ and the Construction of Human Identity. American Anthropologist, 100: 690-702. https://doi.org/10.1525/ aa.1998.100.3.690)
In its implementation, race was presented as if it stemmed from biology. Because of this connection to biology, beliefs about the intellectual and physical capabilities of a racialized group were considered fixed,” “immutable,” and unable to be changed. So a person from a “race” perceived as “unintelligent” or “subhuman” was considered to be that based on biology rather than education, environmental or other external factors that might impact learning capacity such as malnutrition. We now know “race” is not genetic—e.g., biological (https://understandingrace.org/ race-is-not-genetic/). Or do we?
Clearly, OMB and Biden missed the science lessons, which has been circulating for several decades that race is a social construction, although racism is real in its impact on human lives.
The Biology of Human Variation I do, however, want
get surgery, radiation or active monitoring. The patients’ cancer was confined to the prostate, a walnut-sized gland that’s part of the reproductive system. Men in the monitoring group had regular blood tests and some went on to have surgery or radiation.
Death from prostate cancer occurred in 3.1% of the active-monitoring group, 2.2% in the surgery group, and 2.9% in the radiation group, differences considered statistically insignificant.
At 15 years, cancer had spread in 9.4% of the activemonitoring group, 4.7% of the surgery group and 5% of the radiation group. The study was started in 1999, and experts said today’s monitoring practices are better, with MRI imaging and gene tests guiding decisions.
Researchers followed more than 1,600 U.K. men who agreed to be randomly assigned to
as politically motivated, “fundamentally wrong.” But he also threw one of his first jabs at the former president in a quip likely to intensify their rivalry. DeSantis said he personally doesn’t “know what goes into paying hush money to a porn star to secure silence over some kind of alleged affair.”
Comments by other potential rivals, eager to convince voters it is time to move on from the former president but also contending with the fact that he remains the most popular figure in the party:
— During a Saturday visit to Iowa, former Vice President Mike Pence called the idea of indicting a former president “deeply troubling.”
— Asa Hutchinson, the former Arkansas governor mulling his own 2024 bid, said he didn’t expect Trump to withdraw from the race after an indictment, though that would be the “right” thing to do.
— Former South Carolina Gov. Nikki Haley, a declared candidate who also served as Trump’s U.N. ambassador, said Monday on Fox News that Bragg’s case was an attempt at scoring “political points,” adding, “You never want to condone any sort of prosecution that’s being politicized.”
“At the end of the day, not one single person’s opinion of him will be any different after indictment than it was before,” veteran GOP operative Terry Sullivan said in an interview. “All of his perceived negatives are already baked into his name ID with voters.”
to make one fact clear—human variation is a real thing. That is, the observable differences we can see or analyze in skin color, hair
“We have more ways now to help catch that the
WHAT ABOUT OTHER TRUMP INVESTIGATIONS?
The New York probe is among many legal woes Trump is facing. The Justice Department is investigating his retention of top secret government documents at his Florida estate, Mar-a-Lago, after leaving the White House, as well as possible efforts to obstruct that probe. Federal investigators are also still probing the Jan. 6, 2021, insurrection and efforts to overturn the election Trump falsely claimed was stolen.
Portions of a report from a special grand jury in Georgia that investigated whether Trump and his allies illegally interfered in the 2020 election in Georgia shows jurors believed “one or more witnesses” committed perjury and urged local prosecutors to bring charges. The former president never testified, but the report didn’t foreclose the possibility of other charges.
WHAT’S NEXT IN NEW YORK?
It’s unclear. Trump declared in a social media post over the weekend that he expects to be taken into custody on Tuesday and urged supporters to protest his possible arrest. However, there has been no public announcement of any time frame for the grand jury’s secret work. A Trump spokesperson said there has been no notification from Bragg’s office.
Law enforcement officials have been making security preparations for the possibility of an indictment
texture, blood types are biological aspects rooted in human variation and our adaptation to geography as well as inherited traits—
disease is progressing before it spreads,” Loeb said. In the U.S., about 60% of low-risk patients choose monitoring, now called active surveillance. Hamdy said the researchers had seen the difference in cancer spread at 10 years and expected it to make a difference in survival at 15 years, “but it did not.” He said spread alone doesn’t predict prostate cancer death. “This is a new and interesting finding, useful for men when they make decisions about treatments,” he said. The Associated Press Health and Science Department receives support from the Howard Hughes Medical Institute’s Science and Educational Media Group. The AP is solely responsible for all content.
in coming days or weeks — or a court appearance by the president himself.
WILL TRUMP BE HANDCUFFED?
Anna Cominsky, a New York Law School professor and former criminal defense lawyer, said that her best guess is that Trump’s lawyers will work out a deal with the prosecutor’s office to avoid the spectacle of an indictment with handcuffs and a perp walk.
“There is a great likelihood that he will selfsurrender, which means you won’t see a 5 a.m. knock on Mar-a-Lago’s door, officers swarming his house and arresting him and bringing him out in handcuffs,” she said. “He would appear at the prosecutor’s office voluntarily and then be processed, fingerprinted and his picture taken. ” Cominsky is less sure that Trump would want to avoid a public appearance for his arraignment, which would come within two days of an indictment. At that time a judge lists the charges and asks if the defendant pleads guilty or not guilt. “He doesn’t shy away from the chaos, so he may want to use this to his advantage,” she said. Associated Press writers Eric Tucker in Washington, Anthony Izaguirre from Tallahassee, Florida, and Bernard Condon and Michael R. Sisak in New York contributed to this report.
we carry both dominant and recessive traits, which can appear
HISPANICS
insightnews.com Insight News •March 27 2023 - April 2 2023 March 27, 2023 - 2, 2023 • Page 5
7
photo/Shawn Lockhart_CDC
and Prevention
cultured in a petri dish at a CDC laboratory. In a CDC paper published by the Annals of Internal Medicine on Monday, March 20, 2023, U.S. cases of the dangerous fungus tripled over just three years, and more than half of states have now reported it.
Insight 2
Health
photo/Hailshadow
Prostate cancer begins when cells in the prostate gland start to grow out of control. The prostate is a gland found only in males.
Nature Is Like God
Sharing Our Stories
 By: W.D. Foster-Graham
By: W.D. Foster-Graham




Book Review Editor



NATURE IS LIKE GOD
By Alyssa and Moriah Miller
This past Saturday, I had the pleasure of attending a Minnesota Black Authors Expo event at the Brooklyn Park Library. The energy was amazing, a great mix and interaction between authors, readers, and their children.

Among the new authors I had the honor of meeting was Alyssa Miller, whose children’s book, Nature Is Like God, is the topic of my review this month.


Co-authored by Miller and her daughter Moriah, the story embraces scriptural texts from Romans, 2 Corinthians, Colossians, and John that illustrate the majesty of the relationship between nature and God, and it is done in such a way that a small child easily grasps these concepts and truth. I must admit, so often children “get it” quicker than adults do, and they run with it.
Throughout the book and the lovely illustrations by Sara Pimental, the Millers show




us the many ways we “see” God through the diverse facets of nature, and the fact that God is everywhere, ever-present, and forever. And interwoven in the illustrations you will find the words “Like God.” As adults, we can and do get caught up in our busy-ness and the cares of the world, and we take nature for granted. However, if we are intentional about taking each day to experience the wonder of nature that’s all around us, it reminds us that God is a God of abundance, how big, how all-encompassing God the Creator is. And there is such a tremendous wonder in seeing it all through the eyes of a child.
Alyssa and Moriah certainly took me back to the days when my son was a child of five and six, and those days are precious memories that touch my heart.
Nature Is Like God is available is available through Wise Ink Creative Publishing, the Minnesota Black Authors Expo, and Miller’s website www.likegodbook.com. Thank you, Alyssa and Moriah, for a beautiful and inspiring parent-child collaboration. For you readers out there, take a moment. Step outside. Be in the present moment of all that nature is and all of whom the Creator is.

Page 6 • March 27 2023 - April 2 2023 March 27, 2023 - 2, 2023• Insight News insightnews.com
612.332.5299 dakotacooks.com 1010 Nicollet Mall Minneapolis, MN KIRK WHALUM Soulful Smooth Sax Star THOMASINA PETRUS SINGS LADY DAY The Best of Billie & Me BENNY GREENSOLO Hard Bop Modern Jazz MARK O’CONNOR CROSSING BRIDGES Americana Strings Master HUNTERTONES FEAT. AKIE BERMISS & CORY WONG ASLEEP AT THE WHEEL feat. Joshua Hedley & Brennen Leigh AVERY*SUNSHINE Joyful Soul & R&B TINSLEY ELLIS & MARCIA BALL: ACOUSTIC SONGS & STORIES TWO SIDES OF TINA SCHLIESKE Side One: Jazz Side Two: Rock MOORE BY FOUR Twin Cities Vocal Legends APR 6 APR 9 APR 11 APR 13 APR 15 APR 12 APR 14 APR 16 APR 8 APR 7 APR 10 sunday, april 9 –11:30am –GINGER COMMODORE & T. MYCHAEL RAMBO As we spend more time indoors, here are some important reminders: GET VACCINATED For more information, visit northpointhealth.org/covid Scan this QR code for more vaccine information FOLLOW VACCINATION GUIDELINES GET VACCINATED IN PUBLIC INDOOR SPACES WEAR A MASK IF YOU HAVE SYMPTOMS OR EXPOSURE TEST YOURSELF
Alyssa Miller
The U.S. Small Business Administration has named Abdirahman Kahin, CEO & Owner of Afro Deli and Grill, as Minnesota’s Small Business Person of the Year for 2023. Kahin will compete for National Small Business Person of the Year during National Small Business Week, which is taking place the first week of May, in Washington DC.

“Minnesota is home to wonderful resilient small businesses who anchor our communities. Rising to the top this year is Afro Deli & Grill, a fast-casual restaurant founded by Abdirahman Kahin,” said SBA’s Minnesota District Director Brian McDonald. “Kahin’s unique business concept coupled with the support of the SBA and his dedication reflects great credit on his business and
Hispanics
From 5
suddenly—like that cousin with red hair who just pops up in a family tree where everyone else›s hair is brown. Eyebrows are raised until it is revealed that there was once a red-headed ancestor way, way back—a recessive inherited biological trait—human variation. Such traits like red hair, blood types, skin color are rooted in biology and our environmental adaptation. Race is not a biological fact. Also, our visible differences have absolutely NO connection to intelligence or wealth or class. The latter are functions of education, access to the means to make wealth, and the social class one into which a person is born— though they may escape birth social class through education and the accumulation of wealth. The North American system of racialization is one used to justify treating certain human beings as subhuman and labeling my ancestors (and now me) as “inferior” in order to exploit our labor, support human trafficking (e.g., the buying and selling of slaves), and to justify the genocide of a nonwhite people, as well as the occupation and appropriation of their indigenous land and strategic resources. The battle with the U.S. government for indigenous rights to land and water is ongoing, with some successes after decades of struggle and protesting (https://www.pbs.org/newshour/ politics/15-native-americantribes-to-receive-580-million-infederal-money-for-water-rightssettlement#:~:text=The%20 U.S.%20Supreme%20Court%20 ruled,any%20given%20 reservation%20has%20existed).
The U.S. racialized social system of stratification remains firmly in place today both formally and informally. Indeed, as many have observed, “Zip code may not be destiny but it operates with the strength of something like gravity. The place you live exerts a terrific pull in one direction or another” (https://www.edpost. com/stories/zip-code-may-notbe-destiny-but-its-as-hard-tofight-as-gravity ). But such social stratification is essential to ensure the perpetuation of white privilege, which was/is built upon the non-privilege of Black, brown, and Indigenous peoples
The fallacious ideology of white superiority is rooted in the presumption of white supremacy, and is part of the foundation of American democracy and its white wealth. Without such a system of so-called superior whites and so-called subordinate Blacks and Indigenous, and more recently Brown/Latinx, there would be virtually NO white wealth.
It is the labor of Black enslaved people and the theft of indigenous land and resources through genocide and/ or disingenuous treaties that have made white wealth and white privilege possible.
These acts of enslavement, human trafficking, genocide, and violated treaties are the facts the “The W.O.K.E Act” legislation in Florida and the anti-CRT (Critical Race Theory) legislation in Iowa want to hide and erase.
Blanqueamiento: On Hispanics
Becoming “White” in America Hispanics are not new to racial politics. They have their own history of how Black and Indigenous people are always at the bottom of the social ladder—
Always! Though theire is a phrase “money whitens,” which means that economic success can move a person up the social ladder, regardless of their ancestry.
Whitening up or blanqueamiento has always been at the heart of the racialization system in Latin America (https://en.wikipedia.org/wiki/
Blanqueamiento ) Even if born in the U.S., Hispanics/Latin Americans, have absorbed a system of racialization in which the goal is to become less Black

has led to impressive growth to allow him to invest back into the local community.”
Afro Deli and Grill is a fusion restaurant that weaves together business, community, and culture that offers freshly made African, Mediterranean, and American food in a fast, fun, and friendly environment. When Abdirahman Kahin immigrated to the United States in 1996 and settled in Minnesota, he attended community college and developed the skills necessary to start his first business, a media production company. As his American dream evolved, he turned to his next venture; a unique restaurant with a new concept “healthy, fresh, assessable African food made to order at an affordable price”.
Afro Deli’s culture is rooted in the belief that good accessible
or Indigenous—e.g., erase any evidence of Blackness—and become recognized as white— those who can participate in “passing.” They rely upon their light-skin color to help them navigate white America—often marrying white and changing their last names, anglicizing the pronunciation, losing their Spanish accent, not teaching their children to speak Spanish, and masking any evidence of their cultural heritage.
Blanqueamiento contrasts sharply with the onedrop (hypodescent) practice in the United States; in effect, one drop of Black blood (ancestry) relegates the person to being identified as “Black.” Such a practice enabled slaveholders who raped Black enslaved women to ensure that the children from such a violent union would always be classified as Black and enslaved, regardless of their appearance. This sexual brutalization of Black women occurred on slave ships and during slavey was considered ‘entertainment” for slaveholders. Indeed, white masters could walk into slave cabins and assert power over Black men by taking Black girls and women, considered property, to use as sexual playthings. The children that came from these encounters account for the rainbow of skin color, hair texture, and other features (now all confirmed by DNA testing) observable in the Black population today. No amount of legislation will be able to erase this fact.
Historically, countries like Venezuela (Café con leche: Race, Class, and National Identity in Venezuela: https://utpress. utexas.edu/9780292790803) and Argentina (The Idea of
Business
food has the power to bring people together. Abdirahman believes food has no borders but has the power to convene people in meaningful ways. Since the first location opened in 2010, Afro Deli has expanded to four total locations across the Twin Cities, with the goal to continue expanding and open Afro Deli’s in more cities across Minnesota and eventually across the country, becoming the first national African restaurant chain in the United States. National Small Business Week 2023 is taking place the first week of May and is a national multiday virtual event open to all. The conference will feature numerous educational panels providing retooling and innovative practices for entrepreneurs as our nation’s small businesses look to
Race in Latin America, 18701940: https://utpress.utexas. edu/9780292738577), advertised in the early 20th Century for Europeans and whites from Latin America to come and whiten the population of enslaved (Afrodescendants), indigenous people and mestizo, the latter a direct result of the Spanish mixing. Venezuela, often viewed as a “white” Latin American country is a good example of the steps taken to whiten the population and leaving those with African ancestry at the bottom.
Wright’s [Café con leche] research suggests that, contrary to popular belief, blacks in Venezuela have not enjoyed the full benefits of racial democracy. He finds that their status, even after the abolition of slavery in 1854, remained low in the minds of Venezuelan elites, who idealized the European somatic type and viewed blacks as inferior. Indeed, in an effort to whiten the population, Venezuelan elites promoted European immigration and blocked the entry of blacks and Asians during the early twentieth century.
And Graham explains in his Introduction,
The idea of race also made it possible, paradoxically, for mestizos and mulattos—by identifying themselves with white elites as against Indigenous and black majorities—to accept theories that justified white domination over “colored“ populations.
These books provide a description of the reality of pervasive and ongoing discrimination that exists throughout Latin America where total mestizaje never occurred and significant percentages of
pivot and recover toward a stronger economy. It also will recognize the national award winners, including the naming

Afrodescendantes are found in Brazil (the largest population of people of African descent outside of Africa—over 50% of Brazil has African ancestry in their DNA), Peru, Costa Rica, Mexico, and Panama. But there are also Black people in Argentina, Ecuador, Columbia, Honduras, Nicaragua, etc. Sheila Walker, Black anthropologist, as well as many others, have documented that “[The] … fundamental roles [of Africans and their descendants] in the creation and definition of the new societies of the “new world,” and their significance in the development of the Atlantic world, have not been acknowledged.” But the efforts to become visible and heard by Afrodescendentes are historic and ongoing. Changing Hispanics/ Latinxs/Latin Americans into a “race” in the U.S. Census will simply aid the practice already in place in throughout the history of Latin American to erase Blackness, to make people with African ancestry disappear while espousing a false myth of racial tolerance or racial democracy. But Afrolatinos refuse to remain hidden or rendered invisible, and are protesting this U.S. Census change, while simultaneously

of this year’s National Small Business Person of the Year.
For registration and additional information on National Small
demanding recognition at home.
So this is my warning— Hispanics/Latinxs/ Latinos Beware. Having white people decide who and what you are is heading into dangerous terrain, and puts whites once again into positions of enormous powers. Race is NOT Real. Don’t be suckered into this fake social categorization; things will only go downhill.
Black people in America know. We have been trying to remove the stigma and shackles of being defined as a “race,” and its collateral damage of individual, structural, and systemic racism, for almost 400 years.
Take it from us Hispanics/Latinxs/Latinos/ Latin American, becoming a “race” is NOT all that.
Additional Readings:
Ignatiev, Noel, How the Irish Became White: https://a.co/d/d56IY6j
Brodkin, Karen, How
Jews Became White Folks and What that says about Race in America: https://a.co/d/fHA0GSm
Roediger, David,
Working Toward Whiteness: How America’s Immigrants
Became White: The Strange Journey from Ellis Island to the Suburbs: https://a.co/d/1HgZhAl
©2023 Irma McClaurin Irma McClaurin (https://linktr.ee/dr.irma /https:// twitter.com/mcclaurintweets) is the Culture and Education Editor for Insight News, a columnist named “Best in the Nation Columnist” by the Black Press of America in 2015, and a commentator on “The Conversation With Al McFarlane” (https://bit.ly/TCWAM). She is a past president of Shaw University and former Associate VP at the University of Minnesota and founding ED of UROC. This activist anthropologist was a recipient of the 2021 American Anthropological Association’s Engaged Anthropology Award, is author of Women of Belize and Editor of the award-winning Black Feminist Anthropology: Theory, Politics, Praxis and Poetics, as well as a former Fulbright Specialist. A collection of her columns, JustSpeak: Reflections on Race, Culture & Politics in America, is forthcoming in 2023. She recently appeared in the 2023 PBS American Experience documentary, Zora Neale Hurston: Claiming a Space and is working on a book-length manuscript entitled Lifting Zora Neale Hurston from the Shadows of Anthropology.



insightnews.com Insight News •March 27 2023 - April 2 2023 March 27, 2023 - 2, 2023 • Page 7
Business Week, visit sba.gov/ NSBW.
Abdirahman Kahin, CEO & owner of Afro Deli & Grill is the Minnesota small business person of the year
photo/afrodeli.com
Abdirahman Kahin, CEO & Owner of Afro Deli and Grill





















































Page 8 • March 27 2023 - April 2 2023 March 27, 2023 - 2, 2023• Insight News insightnews.com

By Mike Stobbe AP Medical Writer
By Mike Stobbe AP Medical Writer
 By Carla K. Johnson AP Medical Writer
By Carla K. Johnson AP Medical Writer

 By: W.D. Foster-Graham
By: W.D. Foster-Graham




























































